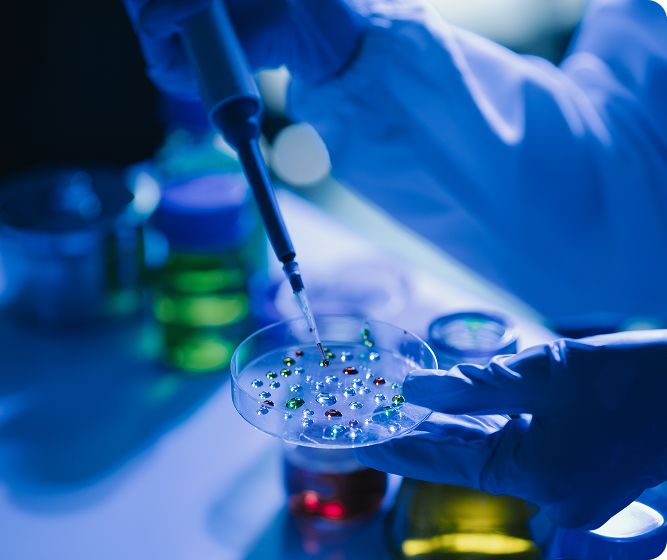

Our Nuclear Medicine division harnesses radioactive materials to deliver advanced diagnostic imaging and targeted therapies. We provide precise, non-invasive solutions for early disease detection and effective treatment, ensuring optimal patient care and outcomes.
The Medical Oncology division specializes in innovative therapies, supported by advanced quality control instruments to enhance patient outcomes and quality of life.
Our Dosimetry Solutions division provides state-of-the-art TLD and OSL badges, alongside in-house services, for accurate radiation measurement and management. We ensure safety and precision in radiation-based treatments, supporting healthcare providers with reliable tools and expertise that are regulated by Federal Authority of Nuclear Medicine (FANR)
The Radiology division offers comprehensive diagnostic imaging services, including ultrasound phantoms, and mammo phantoms. Our expert radiologists and advanced technology deliver high-quality imaging for accurate diagnosis and effective treatment planning.
At Modawina, we carefully select our exclusive surgical solutions in collaboration with internationally renowned medical manufacturers. Designed to support everything from routine procedures to highly complex surgeries, our products empower surgeons with the precision, reliability, and confidence they need to deliver outstanding patient care.
Delivering advanced dental solutions that combine premium equipment, innovative materials, and cutting-edge digital workflows. Modawina supports clinics and hospitals in providing sustainable, precise, and efficient oral care—enhancing outcomes for both clinicians and patients.
Providing advanced diagnostic and research solutions, including high-quality immunohistochemistry (IHC) antibodies, and rapid testing kits. We empower healthcare professionals with accurate, reliable results and innovative tools for faster, more precise diagnoses and effective treatments, enhancing patient care and performance outcomes
We provide advanced physiotherapy, sport medicine and rehabilitation, and exoskeleton robotics solutions designed for healthcare professionals to enhance treatment accuracy, streamline workflows, and improve patient outcomes. Combining innovative technology with proven rehabilitation methods, we help clinicians speed up recovery, reduce pain, and restore mobility.
As a leading healthcare distributor in the GCC, MMC is dedicated to enhancing patient care through premium products and customized solutions. With expertise spanning diverse healthcare fields, we empower medical professionals with advanced tools to improve treatment and patient outcomes.
As a partner of some of the world’s leading manufacturers of medical equipment, MMC offers a highly specialized and diverse line of products such as Nuclear Medicine, Medical Oncology, Dosimetry solutions, Radiology, Surgical instrument, Dental, Laboratory & Physiotherapy.
Learn More About Us
Dedicated to delivering quality solutions that improve patient care & outcomes.
Ensuring reliable access to trusted healthcare products & services for providers.
Prioritizing our customers with exceptional products, services, & ongoing support.
Delivering innovative, high-standard healthcare solutions for better patient care.
We cater to frontline institutions and professionals, equipping them with cutting-edge medical solutions to enhance patient care and operational efficiency.
MMC is licensed by FANR and the Ministry of Environment in the UAE and Oman to handle the import/export of radioactive materials. We collaborate with these government bodies to ensure compliance, safety, and efficient approvals.
We’re here to assist you! Whether you have questions or need more information, our team is ready to help. Expect a response within 24-48 hours during business days. We look forward to connecting with you and supporting your healthcare needs.
Office 405 Bldg. 99, Oud Metha Dubai, UAE, P.O.BOX: 29971
M-44 Plot14, Store# 3, Abu Dhabi, UAE, P.O.BOX: 92990
Ghala Al Sanaiah, Building 245, Office 11, P.O. Box 2652
Fax Us: +968 2 2005184